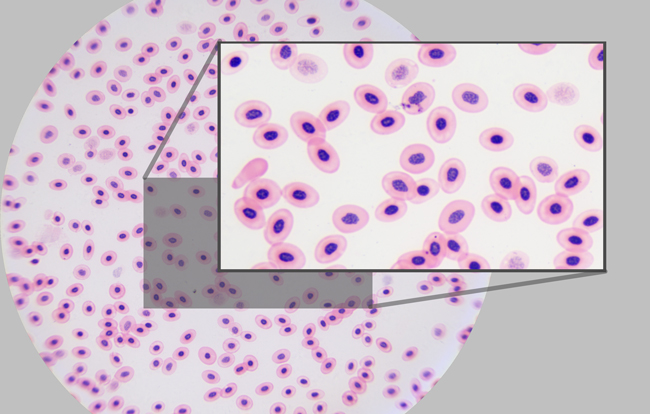

特徴FEATURES
モニタ上でリアルタイム像の閲覧・共有が可能
APD-3500CMは顕微鏡本体・カメラ・HDMIモニタ一体型。付属のモニタ上で、リアルタイム像の確認や撮影済静止画・動画の再生ができ、院内スタッフ間や飼い主様への共有も容易です。
市販の外部モニタも使用でき、大型4Kモニタやプロジェクタ等に映像出力することで、多人数でのディスカッション・カンファレンスにもご利用いただけます。
※映像信号4Kもしくは1080pに対応したHDMIモニタをご利用ください。

Wi-Fiによる無線接続でタブレット・スマートフォン使用可能
Wi-Fiルータを介した無線接続対応。iPadやiPhone等のタブレット・スマートフォンに接続して利用でき、顕微鏡設置場所と離れた場所からの映像確認・撮影操作が可能です。
Wi-Fiルータはご所有のものをご利用いただけるほか、Wi-FiルータをセットにしたAPD-3500CWもご用意しております。
※使用するWi-FiルータはWi-Fi 5(IEEE802.11ac)の通信規格をサポートしている必要があります。

管理しやすい汎用的なデータファイル
撮影データは一般的な画像データ(静止画:.jpg/.tif等、動画:.mp4等)として保存されるため、データの移動や、電子カルテシステム等の院内データベースでの管理も容易です。
撮影データはSDカード・USBメモリ(HDMIモード)もしくは使用しているパソコン・タブレット・スマートフォン等端末(Wi-Fiモード/Ethernetモード/USBモード)のストレージに保存されます。

高精細4K解像度の撮影
4Kカメラによる高精細かつ色再現性に優れた静止画・動画の撮影が可能です。

接眼レンズ観察よりも強拡大なカメラ撮影像
接眼レンズ観察視野の中心部がより強拡大な像として撮影されるため、真菌(カビ類)・寄生虫・結晶等の微小物の観察に有用です。
動物病院での病理検査用として多用される総合倍率100倍~400倍に対応
4倍・10倍・20倍・40倍・100倍の5種の対物レンズが標準付属。特に10倍・20倍・40倍対物レンズ(総合倍率100倍・200倍・400倍)は、動物病院での検査に多く用いられます。
ライト・ギムザ染色やディフクイック染色を行った血液標本、皮膚上の真菌類やヒゼンダニ・ツメダニ等のダニ類、糞尿中の寄生虫、ストルバイトやシュウ酸カルシウム等の尿路結石の原因となる結晶の観察に適しています。

平坦性の高い対物レンズで視野の端までクリアに観察可能
像平坦性の高いプランアクロマート対物レンズを採用。視野中心に焦点を合わせた場合に、視野全体の90~95%程度に同時に焦点が合うため、視野の端と端にある対象物でも、試料の位置調整をせず比較できます。

プランアクロマート対物レンズの観察像

アクロマート対物レンズの観察像
各商品には以下のものが含まれています。
APD-3500CM
- 生物顕微鏡BX-3500TL
- マルチインターフェース4KカメラFLOYD-4K
- スライドグラスプレクリン水切放
- カバーグラス
- 13.3インチ型HDMIワイドLCDモニタJE133N










